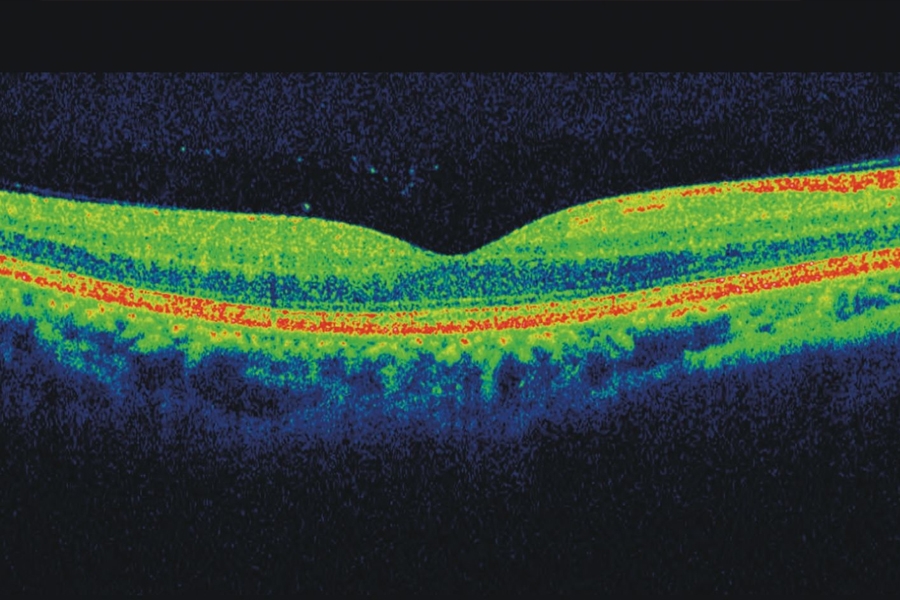

¿Qué Patologías Oculares podemos diagnosticar mediante un examen de Tomografía de Coherencia Óptica?
Mediante la OCT nos permite analizar las diferentes partes de la retina y las relaciones que tiene con otras estructuras del globo ocular como la coroides y el humor vítreo, permitiéndonos un diagnóstico temprano de la patologías del polo posterior del ojo más frecuentes:
- Detección y seguimiento del Glaucoma.
- Degeneraciones maculares (sobre todo las asociadas a la edad o DMAE).
- Edemas maculares.
- Retinopatía Diabética.
- Agujero macular.
- Desprendimiento de Retina.
- Degeneración Miopía.
- Toxoplasmosis.
- Membranas epiretinianas.
- Coroidopatia central serosa.
- Distrofias retinianas (enfermedades hereditarias).